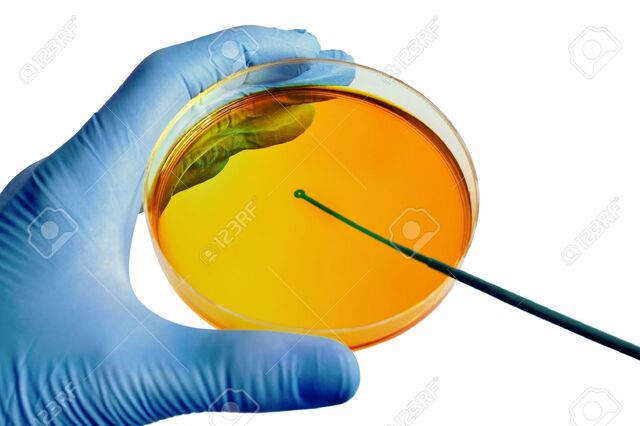
La teoría microbiana sin Pasteur y Koch.

Historia de los conceptos de causa y enfermedad: paralelismo entre la Medicina y la Fitopatología
-
Curanderismo como practica medicinal, realizada por religiosos y encantadores a los cuales se les atribuía una propiedad misteriosa, teórica conocida como punitiva.
-
Se le atribuia las enfermedades a entidades malignas y sobrenaturales en las culturas primitivas.
-
Se le atribuye a las estrellas y planetas el origen de las enfermedades, causantes de pestes, de gran relevancia en el contexto agrícola, constituía una guía basada en los movimientos lunares
-
esta compuesta por tres vertientes: teoría ayurvedica, fuerzas opuestas yin-yang y la de Hipócrates, rompiendo la concepción divina de la enfermedad, siendo la enfermedad de como una alteración interna y externa
-
surgió a raíz de la insalubridad generada por las grandes ciudades y la proliferación de malos olores, siendo los miasmas exhalaciones pútridas por el material vegetal y animal en descomposición, como resultado se desarrollo la ingeniería sanitaria
-
La teoría se fundamento en la observación experimental, se desarrollo el concepto de causa especifica, presencia y ausencia en el hospedero.
-
Inoculación de plantas sanas con hongos previamente identificados comprobando la causa y el efectos
-
Friedrich Hoffmann, elaboró la teoría de la "patología
de sólidos" Considera que el
cuerpo es el resultado de la interacción mutua entre
sólidos y líquidos, -
una enfermedad infecciosa,
tanto en el hombre como en las plantas, es un proceso
dinámico derivado de una cadena factorial -
Clasificación de enfermedades Augustin Grisolle,se refirió a "venenos sépticos", "secreciones mórbidas", "fiebres" e "inflamaciones", Georges Dieulafoy, consideró tres tipos de enfermedades, tales como "enfermedades claramente parasíticas" debidas a hongos, "afecciones sépticas"
Want to make a timeline like this?
Use Timetoast to turn dates, events, milestones, and phases into a clear visual timeline you can build and share. Timetoast is a timeline maker for work, school, research, and stories.